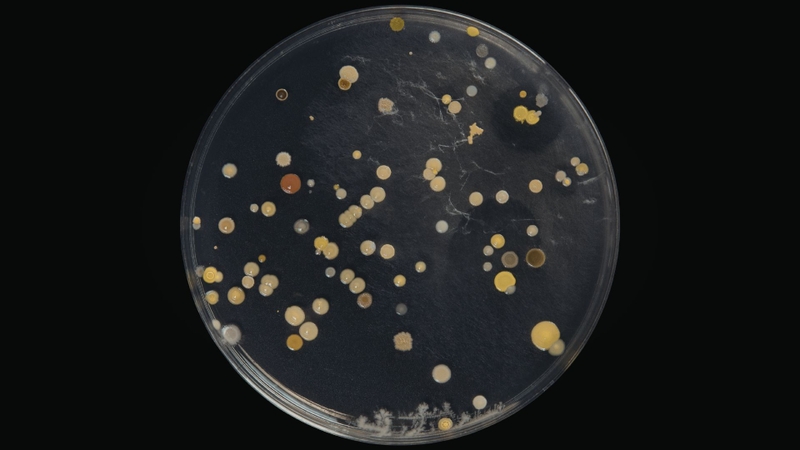
Betula pendula tar oil thường được biết đến với đặc tính kháng khuẩn và kháng nấm

02/04/2026
Mặc định
Lớn hơn
Betula pendula tar oil là dầu hắc ín thu được từ gỗ hoặc vỏ cây bạch dương bạc (Betula pendula). Thành phần này chứa nhiều hợp chất phenolic và hydrocarbon thơm, được biết đến với đặc tính sát khuẩn, kháng nấm và hỗ trợ giảm viêm trên da. Vì vậy, Betula pendula tar oil thường được sử dụng trong một số chế phẩm chăm sóc da hoặc sản phẩm hỗ trợ điều trị các bệnh da liễu như vảy nến và viêm da. Tuy nhiên, do chứa các hợp chất có hoạt tính mạnh, việc sử dụng cần đúng liều lượng và thận trọng khi dùng trên vùng da nhạy cảm.
Betula pendula tar oil là dầu hắc ín thu được từ quá trình chưng khô gỗ hoặc vỏ của cây bạch dương bạc (Betula pendula), một loài cây thuộc họ Betulaceae phân bố rộng rãi ở châu Âu và một số vùng ôn đới của châu Á. Trong quá trình nhiệt phân gỗ trong điều kiện thiếu oxy, các thành phần cấu trúc của gỗ như lignin và cellulose bị phân hủy, tạo thành một hỗn hợp dầu sẫm màu chứa nhiều hợp chất hữu cơ có hoạt tính sinh học. Nhờ đặc tính sinh học đặc biệt, Betula pendula tar oil đã được sử dụng từ lâu trong các chế phẩm chăm sóc da và một số ứng dụng dược liệu truyền thống.
Về thành phần hóa học, Betula pendula tar oil là một hỗn hợp phức tạp bao gồm nhiều hợp chất phenolic, cresol, guaiacol và các hydrocarbon thơm khác. Những chất này góp phần tạo nên đặc tính kháng khuẩn, kháng nấm và hỗ trợ giảm viêm của dầu hắc ín bạch dương. Chính vì vậy, thành phần này đôi khi được đưa vào các sản phẩm bôi ngoài da nhằm hỗ trợ chăm sóc một số tình trạng da liễu như viêm da, vảy nến hoặc các vấn đề da liên quan đến nhiễm vi sinh vật.
Trong lĩnh vực da liễu, các chế phẩm chứa tar từ thực vật, bao gồm Betula pendula tar oil, thường được sử dụng với mục đích làm giảm tình trạng bong vảy, ngứa và viêm trên da. Cơ chế tác dụng được cho là liên quan đến khả năng ức chế sự phát triển của một số vi khuẩn và nấm trên bề mặt da, đồng thời làm chậm quá trình tăng sinh tế bào biểu bì quá mức – yếu tố thường gặp trong các bệnh da mạn tính như vảy nến. Ngoài ra, một số hợp chất phenolic trong dầu còn có khả năng hỗ trợ làm sạch và bảo vệ da trước tác động của vi sinh vật.
Tuy nhiên, do là sản phẩm của quá trình nhiệt phân gỗ nên Betula pendula tar oil chứa nhiều hợp chất hoạt tính mạnh. Khi sử dụng ở nồng độ cao hoặc trên vùng da nhạy cảm, thành phần này có thể gây kích ứng, đỏ da hoặc tăng nhạy cảm với ánh sáng. Vì vậy, các chế phẩm mỹ phẩm hoặc dược phẩm có chứa tar dầu bạch dương thường được kiểm soát chặt chẽ về nồng độ và chỉ dùng ngoài da theo hướng dẫn của nhà sản xuất hoặc chuyên gia y tế.
Ngày nay, Betula pendula tar oil chủ yếu được sử dụng trong một số sản phẩm chăm sóc da truyền thống, xà phòng y khoa hoặc chế phẩm hỗ trợ điều trị da liễu. Dù không phải là hoạt chất điều trị chính trong y học hiện đại, thành phần này vẫn được quan tâm nhờ nguồn gốc tự nhiên và đặc tính sinh học đặc trưng của các hợp chất phenolic có trong dầu hắc ín từ cây bạch dương.

Betula pendula tar oil là dầu hắc ín thu được từ quá trình chưng khô (dry distillation hoặc pyrolysis) gỗ hoặc vỏ của cây bạch dương bạc Betula pendula. Đây là phương pháp cổ điển đã được sử dụng từ lâu trong công nghiệp hóa chất và dược liệu để tách các hợp chất hữu cơ từ nguyên liệu thực vật chứa lignin và cellulose.
Trong giai đoạn chuẩn bị nguyên liệu, gỗ hoặc vỏ cây bạch dương được thu hoạch, làm sạch và cắt nhỏ để tăng diện tích tiếp xúc. Nguyên liệu sau đó được đưa vào thiết bị chưng khô kín, nơi quá trình gia nhiệt diễn ra trong điều kiện thiếu hoặc không có oxy. Nhiệt độ thường được duy trì trong khoảng 300 - 500°C. Ở điều kiện này, các polymer tự nhiên của gỗ như cellulose, hemicellulose và lignin bắt đầu phân hủy nhiệt, tạo ra nhiều hợp chất hữu cơ dễ bay hơi.
Các sản phẩm bay hơi sinh ra trong quá trình nhiệt phân sẽ đi qua hệ thống làm lạnh và ngưng tụ để tạo thành hỗn hợp chất lỏng gồm nhiều pha khác nhau. Phần dầu sẫm màu, giàu hợp chất phenolic và hydrocarbon thơm, chính là Betula pendula tar oil. Ngoài dầu hắc ín, quá trình chưng khô còn tạo ra các sản phẩm phụ khác như khí dễ cháy (CO, CO₂, methane) và than gỗ.
Sau khi thu được sản phẩm thô, dầu tar có thể được tách và tinh chế sơ bộ bằng các bước như lắng, lọc và đôi khi chưng cất phân đoạn. Mục tiêu của các bước này là loại bỏ tạp chất rắn và phân tách một phần các hợp chất bay hơi không mong muốn. Thành phẩm cuối cùng thường là một chất lỏng sẫm màu, có mùi khói đặc trưng, chứa nhiều thành phần hóa học như phenol, cresol, guaiacol và các dẫn xuất thơm khác.
Trong sản xuất hiện đại, quy trình nhiệt phân thường được kiểm soát chặt chẽ về nhiệt độ, thời gian gia nhiệt và điều kiện môi trường nhằm đảm bảo thành phần hóa học ổn định và an toàn khi sử dụng trong các chế phẩm ngoài da. Việc kiểm soát quy trình cũng giúp giảm sự hình thành các hợp chất không mong muốn có thể gây kích ứng da.

Cơ chế tác dụng của dầu hắc từ cây Betula pendula được cho là liên quan đến khả năng khử trùng, sát khuẩn nhẹ và gây kích thích tại chỗ nhẹ. Những tác động này có thể kích thích các thụ thể tại mô, từ đó thúc đẩy vi tuần hoàn tại vùng da bị tổn thương và hỗ trợ quá trình tái tạo mô. Vì vậy, dầu hắc từ bạch dương thường được xem là có đặc tính sát khuẩn và góp phần thúc đẩy hiện tượng tăng sừng của da.
Khi được bào chế dưới dạng thuốc mỡ hoặc chế phẩm bôi ngoài da, dầu hắc từ Betula pendula có thể tạo cảm giác ấm tại chỗ và hình thành một lớp bao phủ trên bề mặt da. Lớp này giúp tạo một lớp bao phủ trên bề mặt da, góp phần bảo vệ vùng da tổn thương khỏi các tác nhân bên ngoài, từ đó tạo điều kiện thuận lợi cho quá trình phục hồi của mô bị tổn thương.
Betula pendula tar oil thường được nhắc đến với đặc tính kháng khuẩn và kháng nấm. Các hợp chất phenolic trong dầu có khả năng ức chế sự phát triển của một số vi sinh vật trên bề mặt da, từ đó góp phần hỗ trợ bảo vệ da khỏi nhiễm khuẩn hoặc nhiễm nấm nhẹ. Nhờ đặc tính này, dầu hắc từ bạch dương đôi khi được đưa vào các chế phẩm dùng ngoài da nhằm hỗ trợ chăm sóc những vùng da dễ bị vi sinh vật tấn công.
Ngoài ra, thành phần này còn được cho là có tác dụng làm dịu viêm và giảm ngứa trên da. Trong một số sản phẩm bôi ngoài da, Betula pendula tar oil có thể giúp làm giảm tình trạng kích ứng, bong vảy hoặc khó chịu ở da. Vì vậy, nó đôi khi được sử dụng trong các chế phẩm hỗ trợ chăm sóc các tình trạng da liễu mạn tính như viêm da hoặc vảy nến.
Một công dụng khác của Betula pendula tar oil là hỗ trợ điều hòa quá trình sừng hóa của da. Các chế phẩm chứa dầu hắc từ bạch dương có thể giúp làm giảm hiện tượng tăng sinh quá mức của tế bào biểu bì, từ đó góp phần cải thiện tình trạng dày sừng hoặc bong vảy trên da. Đồng thời, khi được bào chế trong thuốc mỡ hoặc kem bôi, thành phần này có thể tạo cảm giác ấm nhẹ tại chỗ và hỗ trợ thúc đẩy vi tuần hoàn tại vùng da được sử dụng.
Bên cạnh các ứng dụng trong da liễu, Betula pendula tar oil cũng được sử dụng trong một số sản phẩm hương liệu và mỹ phẩm, đặc biệt là trong ngành nước hoa. Mùi khói đặc trưng của dầu hắc bạch dương giúp tạo nên sắc thái hương gỗ, da thuộc hoặc khói, thường được dùng để tăng chiều sâu cho các công thức hương.
Betula pendula tar oil chủ yếu được sử dụng ngoài da và thường có mặt trong các chế phẩm như thuốc mỡ, kem bôi, xà phòng y khoa hoặc một số sản phẩm chăm sóc da chuyên biệt. Do có hoạt tính sinh học mạnh và mùi đặc trưng của dầu hắc ín, thành phần này thường được dùng với nồng độ thấp và đã được pha chế sẵn trong sản phẩm thay vì sử dụng trực tiếp ở dạng nguyên liệu thô.
Trong các chế phẩm da liễu, Betula pendula tar oil thường được bôi một lớp mỏng lên vùng da cần chăm sóc, với tần suất 1 - 2 lần mỗi ngày hoặc theo hướng dẫn của nhà sản xuất. Khi sử dụng, cần làm sạch và lau khô vùng da trước khi bôi để giúp hoạt chất tiếp xúc tốt hơn với bề mặt da. Một số sản phẩm có thể được thiết kế để lưu lại trên da trong thời gian nhất định nhằm phát huy tác dụng làm dịu, hỗ trợ giảm ngứa hoặc bong vảy.
Trong các sản phẩm làm sạch như xà phòng hoặc dầu gội y khoa, Betula pendula tar oil được dùng với mục đích hỗ trợ chăm sóc da đầu hoặc da cơ thể. Người dùng thường tạo bọt với nước, thoa lên vùng da cần làm sạch, giữ trong thời gian ngắn rồi rửa lại bằng nước. Cách sử dụng này giúp tận dụng đặc tính kháng khuẩn và làm sạch của thành phần mà vẫn hạn chế nguy cơ kích ứng.
Khi dùng Betula pendula tar oil, cần tránh bôi lên vùng da bị trầy xước sâu, vết thương hở hoặc vùng da rất nhạy cảm như quanh mắt và niêm mạc. Ngoài ra, do dầu hắc có thể làm tăng độ nhạy cảm của da với ánh sáng, người dùng nên hạn chế tiếp xúc trực tiếp với ánh nắng mạnh ngay sau khi bôi sản phẩm.

Trong lĩnh vực mỹ phẩm, Betula pendula tar oil được sử dụng với lượng nhỏ trong một số sản phẩm nhờ mùi khói gỗ đặc trưng và các đặc tính sinh học của nó. Thành phần này đôi khi được đưa vào các công thức nước hoa để tạo nốt hương da thuộc hoặc hương khói, giúp tăng chiều sâu và độ ấm cho mùi hương. Ngoài ra, dầu hắc từ bạch dương cũng có thể xuất hiện trong một số sản phẩm chăm sóc da hoặc da đầu, nơi nó được sử dụng nhằm hỗ trợ làm sạch da và cải thiện cảm giác khó chịu trên da.
Dầu hắc ín từ Betula pendula được dùng trong một số chế phẩm da liễu không kê đơn nhằm hỗ trợ chăm sóc các tổn thương da như vết thương ngoài da, vết loét hoặc loét do tì đè khi nằm lâu. Ngoài ra, thành phần này cũng có thể xuất hiện trong các sản phẩm dùng ngoài da để hỗ trợ xử lý một số tình trạng viêm nông, chẳng hạn như viêm tĩnh mạch huyết khối nông hoặc viêm quầng da.
Trong các chế phẩm dược phẩm, dầu hắc từ Betula pendula chỉ được sử dụng để bôi ngoài da và thường được phối hợp với các tá dược như dầu thầu dầu nhằm tạo nền bôi thích hợp và cải thiện khả năng phân tán của hoạt chất trong sản phẩm.

Các lưu ý khi sử dụng Betula pendula tar oil: